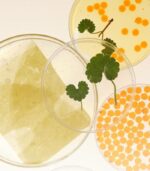
Heveblue - Salmon Caring Centella Green Mask Pack

Heveblue – Salmon Caring Centella Green Mask Pack je zklidňující maska obohacená o salmon komplex a extrakt z Centella Asiatica. Zaměřuje se na obnovu poškozené bariéry, hydrataci a zjemnění podrážděné pokožky. Lehká, příjemně chladivá textura se rychle vstřebává a okamžitě dodává pocit komfortu. Maska pomáhá pleti regenerovat po stresu, sluneční zátěži nebo používání aktivních látek.
Proč si zamilujete Heveblue – Salmon Caring Centella Green Mask
Maska využívá kombinaci salmon peptidů a centelly, aby podpořila obnovu pleti a zklidnila přecitlivělá místa. Salmon komplex dodává výživu a pomáhá posilovat elasticitu, zatímco centella zmírňuje zarudnutí a podporuje regeneraci. Hydratační složky udržují pleť jemnou a vláčnou, takže po sejmutí masky působí svěže a vyrovnaně.
Klíčové složky a jejich benefity
Salmon Complex (peptidy & proteiny) – podporuje regeneraci a zlepšuje pružnost.
Centella Asiatica – zklidňuje podráždění a obnovuje kožní bariéru.
Hyaluronic Acid – hydratuje a udržuje vláčnost pokožky.
Niacinamide – sjednocuje tón a posiluje bariéru.
Green Tea Extract – působí antioxidačně a osvěžuje.
Hlavní účinky Heveblue – Salmon Caring Centella Green Mask Pack
-
Zklidňuje podráždění a redukuje zarudnutí.
-
Posiluje kožní bariéru a podporuje regeneraci.
-
Hydratuje a udržuje pleť pružnou.
-
Zanechává pokožku jemnou a vyživenou.
-
Vyrovnává tón pleti a dodává přirozený glow.
Pro jaký typ pleti je vhodná?
-
Citlivá a podrážděná pokožka.
-
Suchá pleť potřebující výživu.
-
Normální až smíšená pleť se slabou bariérou.
-
Ideální po slunění nebo aktivních látkách (AHA, retinoidy).

Získejte
Získejte 






























Recenze
Zatím zde nejsou žádné recenze.